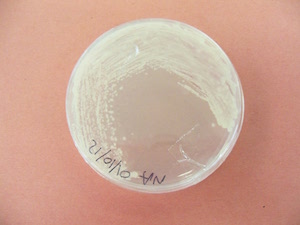

Inledning
Inledning

Tid för detta
Laborationen tar c:a 20 minuter att genomföra (ej medräknat tid för autoklavering).
Material
Varje grupp behöver
|
Gemensamt behövs
|
Gör såhär
- Märk Schott-flaskan med dina initialer, dagens datum och innehåll i flaskan (NA eller NB)
- Häll upp 100 ml avjonat vatten i flaskan
- Väg upp lämplig mängd NA eller NB i ett vågskepp (bakform)
- Häll pulvret i vattnet i Schott-flaskan
- Skruva åt korken, och värm flaskan i mikrovågugnen. Detta görs för att pulvret ska lösa sig i vattnet.
- När pulvret är någorlunda löst, kan man sätta flaskan i autoklaven.
- Autkoklavera lösningarna vid 121 °C enligt instruktioner från tillverkaren av autoklaven.
Observera
- Schott-flaskor är så pass hållbara att det går utmärkt att ha korken väl åtskruvad i autoklaven. Då slipper man risken att få kondensvatten in i odlingsmediet.
- Låt flaskorna svalna tills man kan hålla dem utan besvär i handen innan du öppnar dem. Annars är det stor risk att man bränner sig på het ånga, som strömmar ut när man öppnar.
Riskanalys
Laborationen är måttligt riskfylld. Det finns risk för brännskador. Dessa behandlas med omedelbar kyla (kallt vatten, gärna is) i minst 20 minuter.



